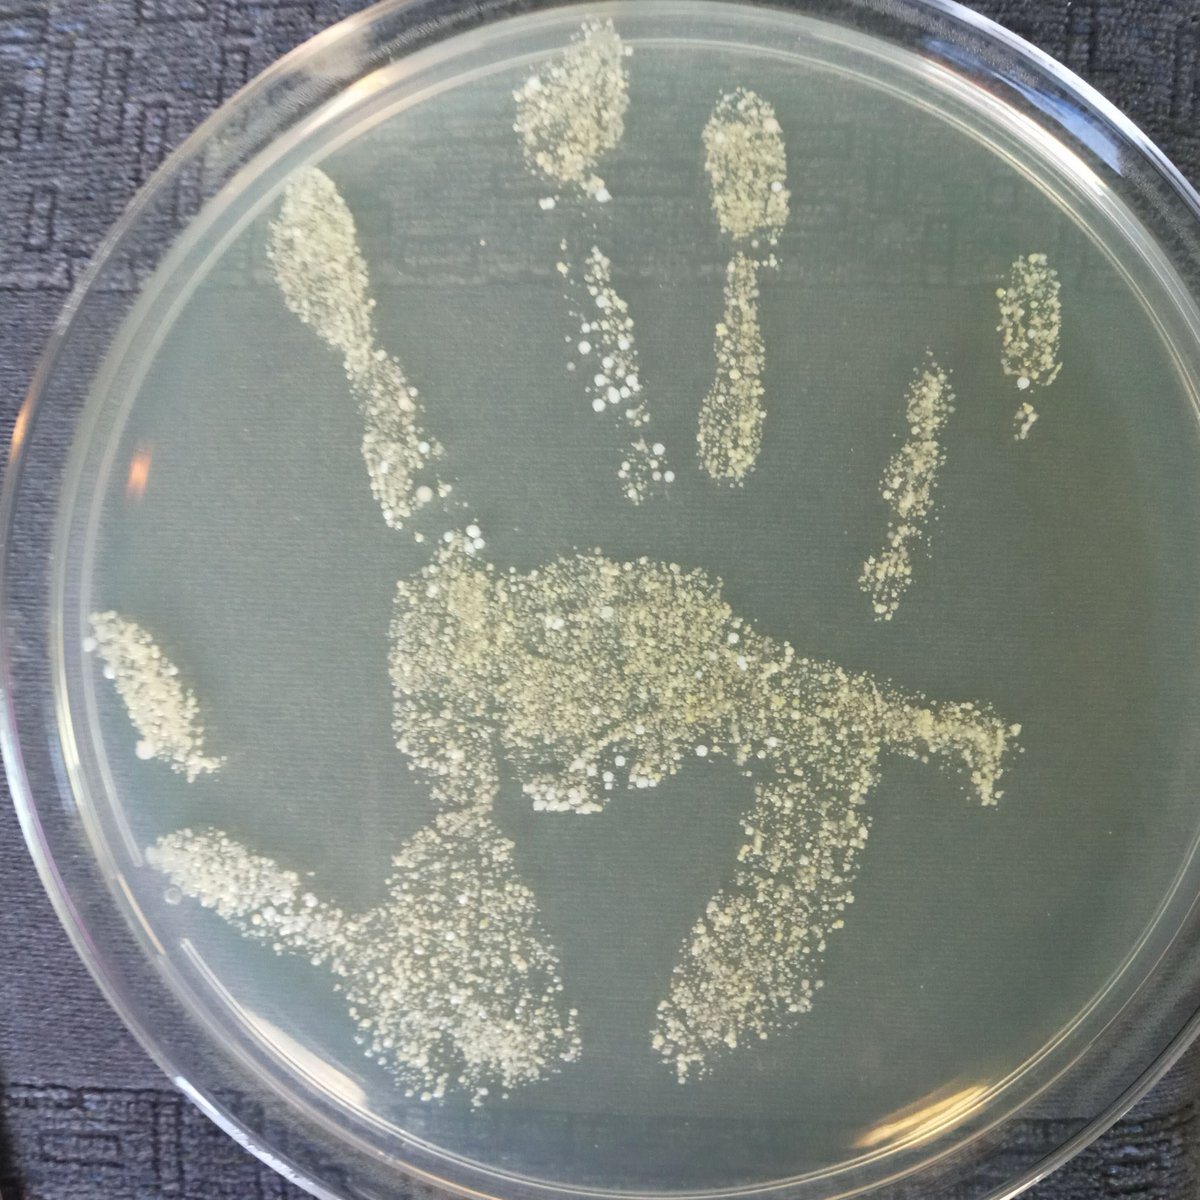
CGIAR_AMRhub tweet media

Sabitlenmiş Tweet

#WorldHealthDay invest in #OneHealth approaches in livestock farming and aquaculture to curb the spread of #AntimicrobialResistance
#WhyLivestockMatter
#AMR
@ILRI @IWMI_ @WorldFishCenter @IFPRI

English
CGIAR_AMRhub
660 posts

@amrhub
@CGIAR AMR Hub, a global research and development partnership for reducing agriculture-associated antimicrobial resistance in LMICs.





❓Pourquoi la résistance aux antibiotiques est un problème de santé qui concerne non seulement l’humain, mais aussi les animaux ? 🎧Les explications de @hung_cenpher codirecteur du Programme de santé animale & humaine @ILRI dans #LeConseilSanté sur @RFI ↓ rfi.my/9Wy4

“AMR is not a one man battle, every stakeholder needs to do their part” - Emmanuel Isingoma, Minister of Agriculture, Uganda. #MyTurnAMRSymposium







